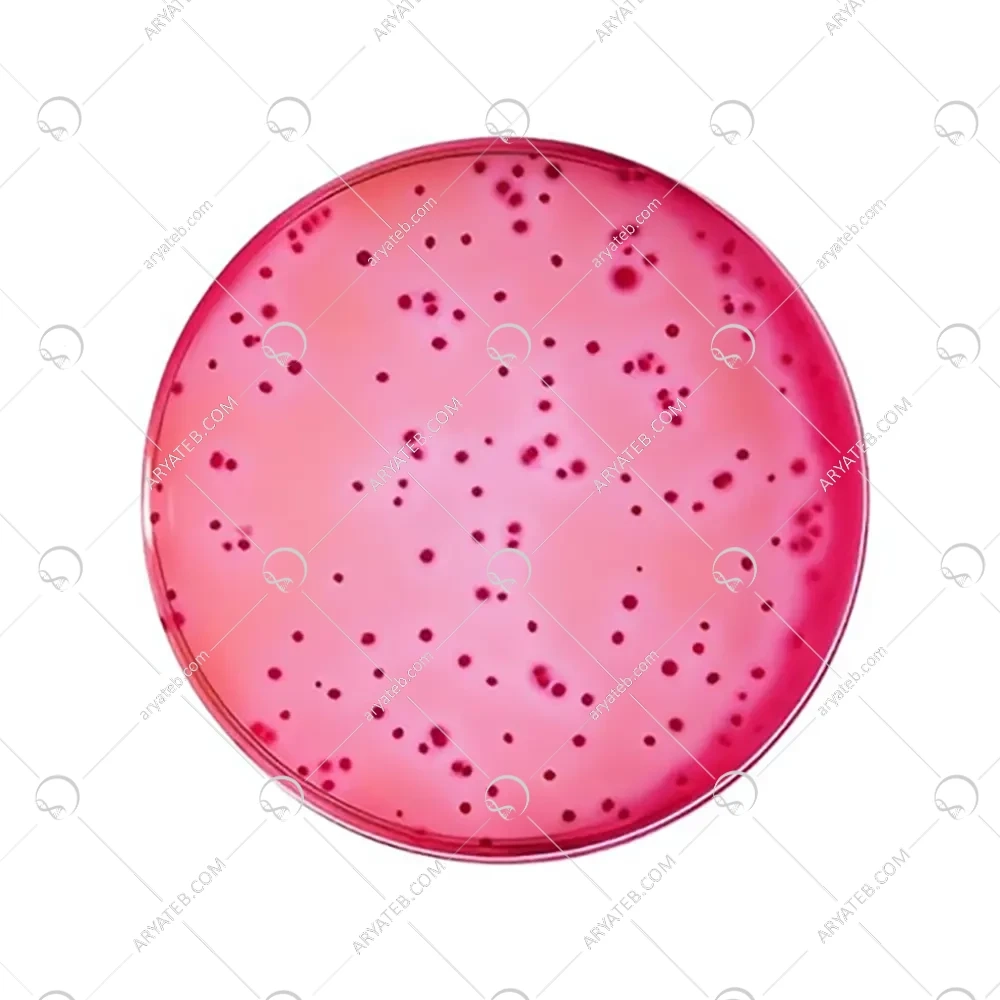

- شناسایی و شمارش کلی فرم های لاکتوز مثبت در شیر و مواد لبنی و مواد غذایی
محیط کشت vrbl
VRBL Agar یک محیط انتخابی برای جداسازی و شمارش کلیفرم ها در آب، شیر و سایر محصولات لبنی، تجهیزات لبنی و سایر مواد غذایی است. محیط VRBL به استفاده همزمان از کریستال بنفش و نمک های صفراوی برای مهار باکتری های گرم مثبت و قرمز خنثی به عنوان شاخص PHمتکی است.
اگر کشت وجود داشته باشد، به این معنی است که میکروارگانیسم در برابر عوامل انتخابی، کریستال ویولت و نمک های صفراوی مقاوم است، بنابراین می توانیم فرض کنیم که سویه یک باسیل گرم منفی است.
محیط کشت ویولت رد بایل لاکتوز
میکروارگانیسمهایی که به سرعت لاکتوز را تخمیر میکنند، کلنیهای بنفش رنگی را ایجاد میکنند که با هالهای بنفش احاطه شدهاند (در مورد اسیدی شدن قوی که با استفاده از لاکتوز مرتبط است). میکروارگانیسم هایی که لاکتوز را تخمیر نمی کنند یا دیرتر تخمیر می کنند، کلنی های رنگ پریده با مناطق سبز رنگ ایجاد می کنند.
دستورالعمل / ترکیبات
پپتون 7.00 گرم
کلرید سدیم 5 گرم
عصاره مخمر 3 گرم
قرمز خنثی 0.03 گرم
نمک های صفراوی 1.5 گرم
کریستال بنفش 0.002 گرم
لاکتوز گرم
آگار 1500 گرم
اجزای تشکیل دهنده، پودر آب شده، را در آب معلق کنید) 39.5 گرم در 1000 میلی لیتر آب تصفیه شده / مقطر).
محیط را برای چند ثانیه می جوشانند تا مواد کاملا حل شوند.
از اتوکلاو یا گرم شدن بیش از حد خودداری کنید.
تا دمای 47 درجه سانتیگراد خنک کنید و در پتری ظروف بریزید.
PH نهایی باید 7.5 + 0.2 باشد.
تفسیر
کلیفرم ها معمولاً با توانایی آنها در تخمیر سریع لاکتوز، تولید اسید و گاز، معمولاً در عرض 24 ساعت، تعریف می شوند. جنس هایی که عموماً انتظار می رود متعلق به این گروه باشند عبارتند از انتروباکتر، کلبسیلا، سیتروباکتر و اشریشیا، به ویژه اشریشیا کلی.
با این حال، گونه های دیگر جنس ها، به عنوان مثال Erwinia و Serratia نیز می توانند لاکتوز را تخمیر کنند، البته به آرامی و برخی از سویه های سیتروباکتر و کلبسیلا، و همچنین سالمونلا آریزونا و هافنیا آلوی، تاخیری یا متغیر را نشان می دهند.
E. coli: رشد خوب، مستعمرات صورتی تا بنفش با هاله
استافیلوکوکوس اورئوس: رشد نمی کند
انتروکوکوس فکالیس: رشد نمی کند
سودوموناس آئروژینوزا مستعمرات: بژ-صورتی.
محیط کشت VRBL کیولب
آریا طب یک شرکت فعال در زمینه فروش محیط کشت میکروبی است که در زمینه فروش محیط کشت VRBL نیز فعالیت دارد. تمامی محصولات آریا طب به صورت آنلاین به فروش می رسد و تمامی سفارشات از طریق پست ارسال می شود. برای کسب اطلاعات بیشتر در مورد فروش محیط کشت VRBL به مطلب زیر توجه فرمایید.
فروش بستر کشت
محیط کشت VRBL یکی از محیط های کشت پرکاربرد در آزمایشگاه ها برای شناسایی و شمارش میکروارگانیسم های لاکتوز مثبت در شیر، محصولات لبنی و مواد غذایی است. تمام اشکال لاکتوز مثبت با تخمیر لاکتوز باعث کاهش pH محیط می شود که به دلیل وجود رنگ قرمز بنفش در محیط کشت VRBL Kevlab می توان کلنی های قرمز رنگ با محیط روشن را شناسایی کرد.
ویژگی های محیط کشت vrbl
- محیط کشت دیفرانسیل انتخابی
- رنگ قرمز
- تشکیل کلونی های قرمز تیره با نور اطراف در صورت مثبت
استفاده از محیط کشت VRBL
- شناسایی و شمارش کلی اشکال لاکتوز مثبت در شیر و لبنیات و مواد غذایی
خرید محیط کشت VRBL
جهت خرید محیط کشت VRBL از شرکت آریا طب می توانید از طریق این صفحه اقدام نمایید. تمامی محصولات آریا طب با کیفیت تضمینی و قیمت مناسب به صورت آنلاین به فروش می رسد. همچنین تمامی محصولات آریا طب از طریق پست ارسال می شود. شما عزیزان می توانید سفارش خود را در کمترین زمان ممکن درب منزل خود سفارش و پرداخت نمایید. جهت کسب اطلاعات بیشتر در مورد خرید محیط کشت VRBL با همکاران ما در واحد فروش آریا طب تماس حاصل فرمایید.
کاربرد
آگار صفراوی قرمز بنفش با لاکتوز (VRBL)، حاوی رنگ صفراوی و قرمز بنفش، بر اساس MacConkey Agar (Cat. 1052) برای تشخیص و شمارش باکتری های تخمیر کننده لاکتوز و تمایز کلی فرم ها یا گروه کولیاروژن ها وموجودات موجود در محصولات لبنی، آب و غذاها از تخمیر غیر لاکتوز ساخته شده است.
پپتون نیتروژن، ویتامین ها، مواد معدنی و اسیدهای آمینه ضروری برای رشد را فراهم می کند. عصاره مخمر منبعی از ویتامین ها، به ویژه از گروه B است.
لاکتوز کربوهیدرات قابل تخمیر کربن و انرژی است. نمک های صفراوی و کریستال ویولت باکتری های گرم مثبت را مهار می کنند.
قرمز خنثی نشانگر PH است. کلرید سدیم الکترولیت های ضروری برای حمل و نقل و تعادل اسمزی را تامین می کند. آگار باکتریولوژیک عامل انجماد است.
انبار
دمای ذخیره سازی : 8 الی 15
پس از باز شدن، پودر را در بسته نگه دارید تا هیدراته نشود.
آدرس ایمیل شما منتشر نخواهد شد. فیلدهای الزامی علامت گذاری شده اند *